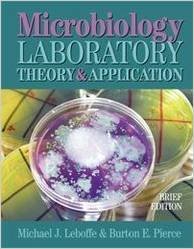
microbiology lab theory and application brief edition

- Title : Microbiology Lab Theory And Application Brief Edition
- ASIN : 0895827050
- Status : Available
- Format File : PDF
- Downloaded in : 94 times
Free Ebooks Microbiology Lab Theory And Application Brief Edition
Find loads of the microbiology lab theory and application brief edition book catalogues in this site as the choice of you visiting this page. You can also join to the website book library that will show you numerous books from any types. Literature, science, politics, and many more catalogues are presented to offer you the best book to find. The book that really makes you feels satisfied. Or that's the book that will save you from your job deadline.
Now, we come to offer you the right catalogues of book to open. microbiology lab theory and application brief edition is one of the literary work in this world in suitable to be reading material. That's not only this book gives reference, but also it will show you the amazing benefits of reading a book. Developing your countless minds is needed; moreover you are kind of people with great curiosity. So, the book is very appropriate for you.
Growing up from elementary to the adult, reading books will let different reasons to believe. Sometime, we need the book because of the job deadline. But in other time, you can read again this microbiology lab theory and application brief edition, for not only the job deadline need but also for eager. So, is reading this book your great eager to read. When you have enough to seek for another book that can't make you feel pleased, you will always look for other sources, won't you? This is why we come to you to help in finding the right book.
Finding this microbiology lab theory and application brief edition as the right book really makes you feel relieved. Even this is just a book; you can find some goodness that can't be got from any other sources. Fulfilling the curious it is sometime very easy, but sometime it needs the big effort. As here, before finding this website to get the book, you may feel so confused. Why? It's because you really need this awesome microbiology lab theory and application brief edition book to read as soon as possible.
